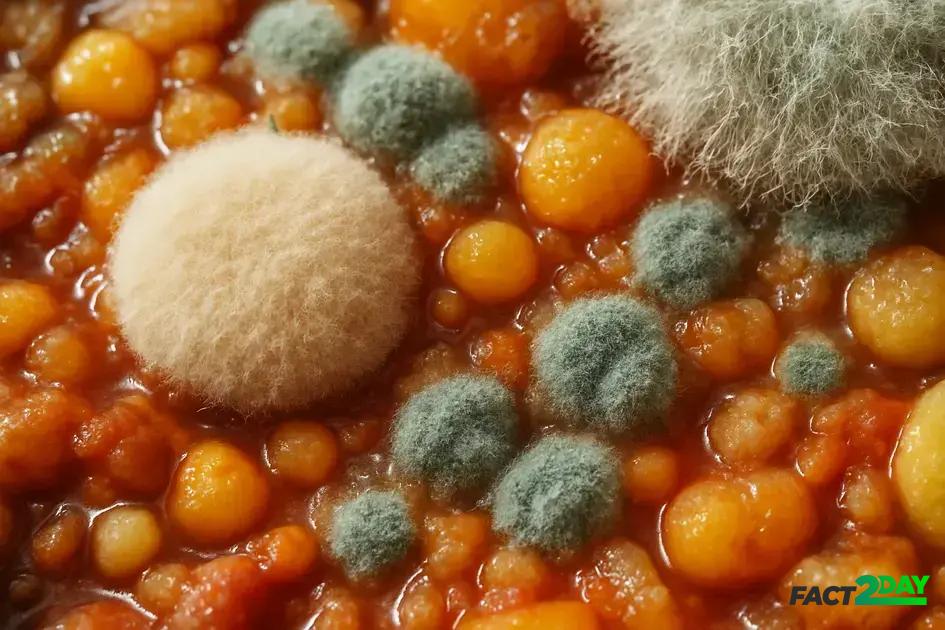

Beyond Yeast: Exploring the Bizarre and Delicious World of Fungal Fermentation in Food
Discover The Hidden World of Fungal Fermentation and unlock the secrets behind unique flavors and textures in your favorite foods.
Exoplanets are worlds orbiting stars beyond our solar system, discovered through techniques like detecting star light dimming, revealing a vast universe filled with diverse planets and the potential for life.
The Hidden World of Fungal Fermentation invites you to explore a fascinating process that transforms ordinary ingredients into extraordinary flavors. Have you ever wondered how fungi other than yeast contribute to the rich textures and tastes in some of our favorite foods? Let’s dive into this bizarre and delicious phenomenon together.
Understanding fungal fermentation: basics and significance
Fungal fermentation is a natural process where fungi break down organic materials to produce food and other valuable products. Unlike common yeast fermentation, which mostly produces alcohol and carbon dioxide, fungal fermentation involves a wider range of fungi, including molds and filamentous species. These fungi help transform foods by releasing enzymes that alter texture, flavor, and nutritional properties.
Key Fungi in Fermentation
Some well-known fungi involved include Aspergillus, which is used in fermenting soybeans for products like soy sauce, and Rhizopus, which plays a role in making tempeh. These fungi break down complex molecules into simpler, flavorful compounds.
Why It Matters
Fungal fermentation not only enhances taste and aroma but also increases the digestibility of foods and sometimes their health benefits. It can also help preserve food naturally, reducing spoilage. This diverse process has shaped many traditional cuisines around the world and continues to inspire new culinary creations.
Types of fungi involved in fermentation processes
Various fungi play crucial roles in fermentation, each contributing unique characteristics to the final food product. The most common groups involved are yeasts, molds, and filamentous fungi. These fungi work by breaking down sugars and other compounds, creating flavors, textures, and aromas that define fermented foods.
Yeasts
Yeasts are unicellular fungi that produce alcohol and carbon dioxide during fermentation. The most well-known yeast is Saccharomyces cerevisiae, commonly used in bread, beer, and wine production. Yeasts help ferment sugars, adding distinctive tangy or alcoholic notes.
Molds
Molds such as Aspergillus oryzae are essential in Asian fermentations like soy sauce and miso. These molds secrete enzymes that break down proteins and starches into simpler compounds, enhancing umami flavors and improving digestibility.
Filamentous Fungi
Filamentous fungi, including Rhizopus species, are used in foods like tempeh. These fungi form dense networks called mycelium that bind food substrates together, creating unique textures and imparting subtle flavors.
Understanding these fungi helps appreciate the diversity and complexity behind many traditional and modern fermented foods worldwide.
How fungal fermentation enhances food flavors and textures
Fungal fermentation plays a key role in creating complex flavors and unique textures in many foods. During fermentation, fungi produce enzymes that break down proteins, fats, and carbohydrates into smaller molecules. These changes give rise to rich tastes and aromas that you won’t find in unfermented foods.
Flavor Development
Enzymatic activity by fungi releases amino acids and sugars that react to produce savory, sweet, and umami flavors. For example, molds like Aspergillus oryzae help develop the deep umami taste in soy sauce and miso by breaking down soy proteins. Yeasts also add fruity and tangy notes by fermenting sugars into alcohols and acids.
Texture Transformation
Fungi contribute to texture by altering the structure of food. In tempeh production, the Rhizopus mold forms a dense mycelium network that binds soybeans together, creating a firm, sliceable texture. In cheeses, fungal molds create distinctive rind textures and creamy interiors.
These biochemical changes not only improve mouthfeel but also make fermented foods easier to digest. The combination of unique flavors and textures is why fungal fermentation is prized in traditional and modern cuisines worldwide.
Health benefits linked to fungal-fermented foods
Fungal-fermented foods offer numerous health benefits that have fascinated nutritionists and food scientists alike. The fermentation process boosts food with probiotics, which are good bacteria and fungi that help balance gut flora and improve digestion.
Improved Digestibility
Fungi break down complex carbohydrates and proteins, making the nutrients easier to absorb. This can be particularly helpful for people with sensitive digestion or certain food intolerances.
Rich in Beneficial Compounds
Many fungal-fermented foods contain bioactive compounds such as antioxidants, vitamins, and enzymes. For instance, tempeh is rich in Vitamin B12, which is essential for vegetarians and vegans.
Supports Immune Health
Probiotic fungi can help stimulate the immune system and reduce inflammation. Regular consumption of fermented foods has been linked to lower risks of infections and chronic diseases.
These benefits show why fungal fermentation is more than just a culinary technique—it’s also a valuable health practice rooted in traditional diets around the world.
Traditional foods made with fungal fermentation worldwide
Fungal fermentation is a cornerstone of many traditional foods around the world, each reflecting unique cultural techniques and flavors. These foods often highlight the versatility and power of fungi in transforming simple ingredients.
Asia
In Asia, soy sauce and miso are produced using molds like Aspergillus oryzae. These fermented delights add rich umami flavors to countless dishes. Another example is tempeh, a staple in Indonesia, made by fermenting soybeans with Rhizopus mold to create a firm, nutritious cake.
Europe
Europe is famous for a variety of fungal-fermented cheeses such as Brie, Camembert, and Roquefort. These cheeses develop their characteristic flavors and textures thanks to molds like Penicillium species, which create the rind and distinctive marbling.
Africa
In parts of Africa, fermented products such as ogi and ogi baba utilize fungal fermentation to soften grains and improve digestibility, while also producing a mildly sour taste.
Americas
Some indigenous American foods use fungal fermentation, such as chicha, a traditional fermented beverage, with fungi playing a supporting role in fermentation alongside yeast and bacteria in some recipes.
These examples demonstrate how fungal fermentation shapes global cuisines by enriching flavors, textures, and nutritional value across diverse food traditions.
Modern innovations in fungal fermentation
Modern advances in fungal fermentation are pushing the boundaries of food production and biotechnology. Scientists and food technologists are exploring new fungal strains and optimizing fermentation conditions to create novel flavors, textures, and nutritional profiles.
Precision Fermentation
Using genetic engineering, researchers tailor fungi to produce specific enzymes or bioactive compounds. This precise control enhances efficiency and consistency in industrial fermentation processes.
Sustainable Food Production
Fungal fermentation is being used to develop sustainable protein sources like mycoprotein, found in popular meat substitutes. These innovations provide environmentally friendly alternatives to traditional animal farming.
Functional Foods and Supplements
Innovative fungal fermentation produces ingredients rich in vitamins, antioxidants, and probiotics. These functional foods aim to support health beyond basic nutrition, targeting immune support and gut health.
Fermentation Technology
New fermentation equipment and monitoring systems allow for better control of temperature, pH, and oxygen levels, improving product quality and reducing waste.
The blend of traditional knowledge and cutting-edge science is transforming fungal fermentation into a vital tool for future food innovations.
The science behind fungal fermentation techniques
The science behind fungal fermentation focuses on how fungi break down complex molecules through enzymatic activity. These fungi produce specific enzymes like amylases, proteases, and lipases that convert starches, proteins, and fats into simpler compounds.
Enzymatic processes
Amylases break down starches into sugars, which fungi and other microbes can ferment. Proteases degrade proteins into amino acids, enhancing flavor and digestibility. Lipases transform fats into fatty acids, contributing to aroma and texture.
Microbial interactions
Fungal fermentation often involves a community of microorganisms working together. Fungi create conditions like pH changes that favor beneficial bacteria, improving fermentation quality and safety.
Environmental factors
Temperature, humidity, and oxygen levels are carefully controlled to optimize fungal growth and enzyme production. These parameters affect fermentation speed and the final product’s characteristics.
Understanding these scientific principles allows producers to refine fermentation methods for consistent, high-quality foods with enhanced flavors and health benefits.
Challenges and safety considerations in fungal fermentation
Fungal fermentation offers exciting opportunities, but it also presents several challenges and safety considerations that must be addressed. Controlling contamination is crucial, as unwanted microorganisms can spoil the product or produce harmful toxins.
Contamination Risks
Environmental exposure and poor sanitation can introduce bacteria or molds that compete with beneficial fungi. This can affect fermentation quality and safety. Maintaining clean equipment and proper hygiene is essential.
Toxin Production
Certain fungi can produce mycotoxins, which are harmful to humans. Selecting safe fungal strains and monitoring fermentation parameters like temperature and pH greatly reduce these risks.
Allergens and Sensitivities
Some people may be allergic to fungal spores or byproducts. Clear labeling and awareness help consumers avoid adverse reactions.
Regulatory Compliance
Producers must adhere to food safety standards and regulations governing fermentation processes. Regular testing and documentation ensure compliance and product safety.
Addressing these factors promotes a safe, high-quality fungal fermentation process that benefits both producers and consumers.
Tips for experimenting with fungal fermentation at home
Experimenting with fungal fermentation at home can be rewarding and fun when done carefully. Start by choosing safe and well-known fungi like Rhizopus for tempeh or Aspergillus oryzae for koji. These are easier to handle and have a rich history of use in food fermentation.
Choose the Right Ingredients
Fresh, high-quality ingredients ensure successful fermentation. Use whole soybeans for tempeh or rice for koji, avoiding any spoiled or moldy materials.
Maintain Cleanliness
Always sterilize utensils and work surfaces to prevent unwanted bacteria or molds from contaminating your fermentation. Clean hands and appropriate storage containers are essential.
Control Temperature and Humidity
Consistent temperature around 86–90°F (30–32°C) is ideal for most fungal fermentations. Use a warm, draft-free spot or a fermentation box. Humidity control is also important to avoid drying or excessive moisture.
Monitor Progress
Check your ferment regularly for off-smells or unusual colors. Some white mold growth is normal, but green or black spots may indicate spoilage.
Start Small
Begin with small batches to understand the process and adjust conditions as needed. Journaling your steps and results can help improve future attempts.
With attention to detail and patience, home fungal fermentation can open doors to new flavors and healthier foods right from your kitchen.
The future potential of fungal fermentation in food industry
The future of fungal fermentation in the food industry holds exciting possibilities for sustainability, nutrition, and innovation. As global demand for alternative proteins and healthier foods rises, fungal fermentation is becoming a key player in meeting these needs.
Sustainable Protein Sources
Mycoprotein and other fungal-based proteins offer environmentally friendly alternatives to meat, requiring less land and water while producing fewer greenhouse gases.
Personalized Nutrition
Advances in biotechnology may allow fungal fermentation to create custom foods tailored to individual health needs, enhancing nutrient delivery and digestion.
Flavor and Texture Innovation
With precise control over fermentation, food creators can develop new tastes and textures that mimic traditional foods or introduce entirely novel culinary experiences.
Waste Reduction
Fungal fermentation can utilize food waste or by-products, transforming them into nutritious ingredients and reducing overall food system waste.
Overall, fungal fermentation is set to become a transformative force in the food industry, combining tradition with cutting-edge science to build a healthier, more sustainable future.
Embracing the Future of Fungal Fermentation
Fungal fermentation offers a unique blend of tradition and innovation that is reshaping the food industry. With its potential to create sustainable proteins, enhance flavors, and reduce waste, it addresses many challenges facing our food systems today.
As research and technology advance, fungal fermentation will likely play a larger role in personalized nutrition and eco-friendly food production. Exploring these developments can open doors to healthier and more delicious food options for everyone.
Understanding and embracing fungal fermentation is a step towards a more sustainable and flavorful future.
